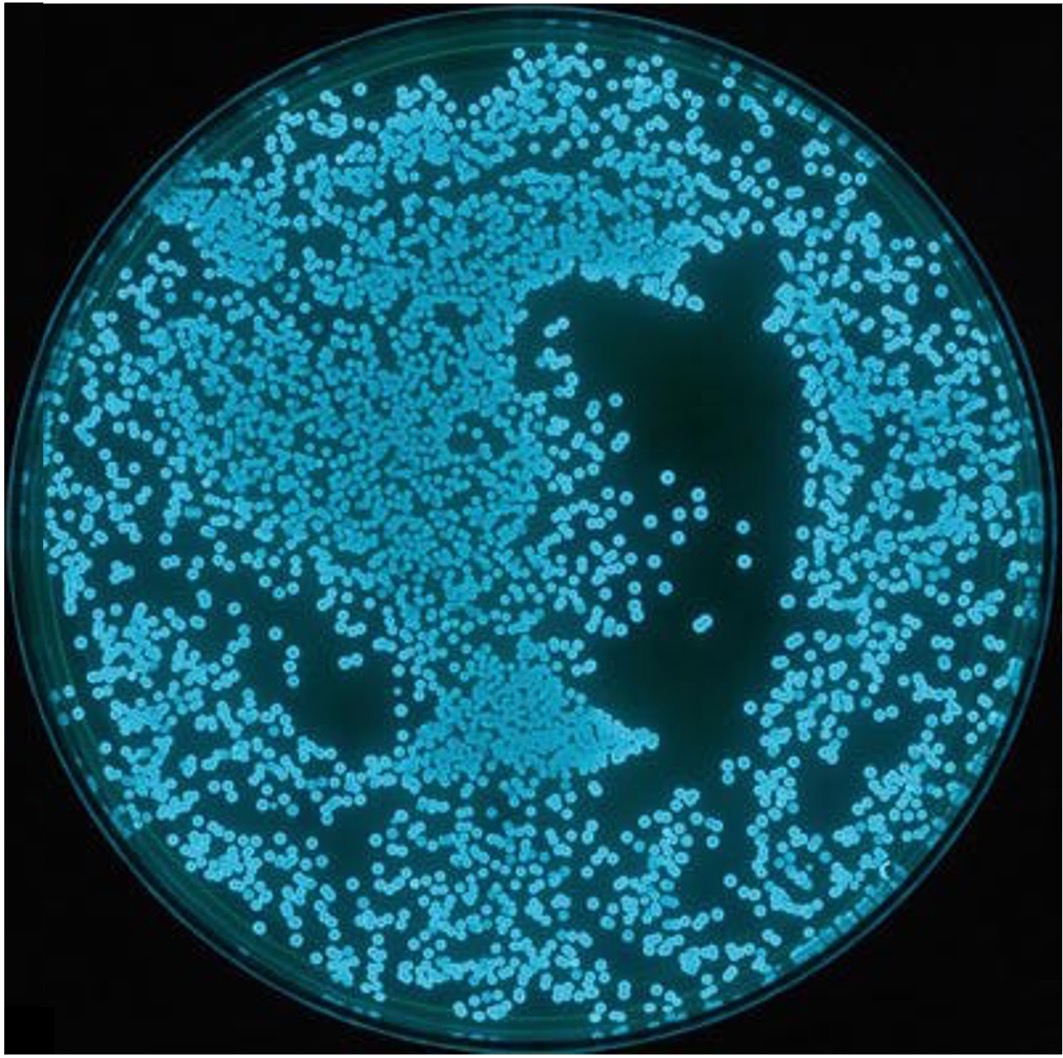
quorum1

Cell Signalling
Cell signalling describes the transmission of chemical signals between interacting cells
-
The cells within a multicellular organism must be able to coordinate in order to maintain homeostasis
-
Communication may also occur between unicellular organisms within any given environment
The process of cell signalling begins with a signalling chemical called a ligand, which is released by a communicating cell
-
The ligand binds to a specific receptor with a complementary binding site, located on (or within) a target cell
-
The binding of the ligand causes a conformational change in the receptor, which triggers a cellular response
-
The process by which a chemical signal is transformed into a cellular response is called signal transduction
Signalling molecules may trigger a variety of cellular responses, including:
-
Changes to gene expression patterns (leading to differentiation within the target cell)
-
Regulation of enzyme activity (leading to changes in metabolic activity levels)
-
Changes in cell size or shape (e.g. muscle contractions)
-
Cell proliferation (leading to organismal growth) or cell death (via apoptosis)
Ligand Binding


Quorum Sensing
Bacterial colonies may communicate using ligands via a process known as quorum sensing – which involves the regulation of cell activity based on population density
-
A quorum represents the minimum number of organisms required for a coordinated process (e.g. synchronised gene expression) to occur
Individual bacterial cells release ligands (autoinducers) that trigger transcriptional changes when a threshold is reached
-
As more bacteria aggregate within a population, more ligand is released into the local environment
-
When a specific concentration of ligand is reached, a synchronised change in activity is triggered within the entire population
Quorum Sensing in Bacteria

Low Density

High Density
Bioluminescence
Quorum sensing can allow certain types of bacteria to achieve bioluminescence
-
Vibrio fischeri release an autoinducer that binds to intracellular receptors within neighbouring bacteria
-
When enough receptors are activated as a consequence of high ligand concentrations, transcription is activated
-
This results in the expression of the enzyme luciferase, which catalyses a reaction that results in bioluminescence
Vibrio fischeri are found within certain species of squid (such as the bobtail squid) and form a mutualistic relationship
-
The bacteria provide camouflage for the squid by lighting up its underside to make it less visible against the brighter surface when viewed from underneath
-
The bacteria in turn benefit from the provision of organic compounds produced by the squid’s metabolic processes
Bioluminescence Example
Vibrio fischeri





